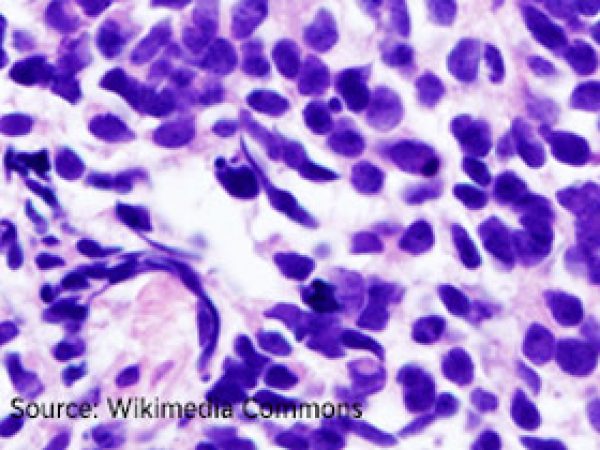
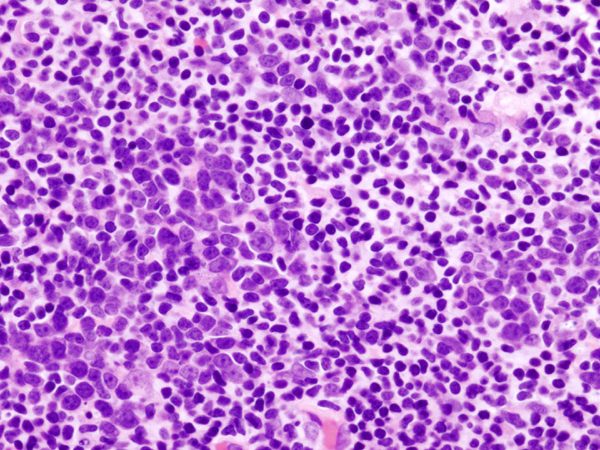

Cancer Types
Cancer isn’t a single disease. The term cancer encompasses many diseases all characterized by the uncontrolled proliferation of cells. Ignoring the body’s signal to stop, malignant cells multiply to form tumors in organs and tissues or, in the case of blood cancers, crowd out normal cells in the bloodstream and bone marrow.